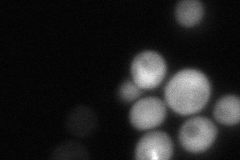
YDL181W
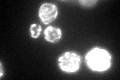
YDL181W
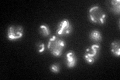
YDL181W

View description
Protein that inhibits ATP hydrolysis by the F1F0-ATP synthase; inhibitory function is enhanced by stabilizing proteins Stf1p and Stf2p; has similarity to Stf1p; has a calmodulin-binding motif and binds calmodulin in vitro
Localization:
Intensity:
Fold change:
Significance:
-
C’ GFP library in SD

mitochondria54.29 -
N' NOP1pr-GFP in SD

mitochondria209.129 -
N' TEF2pr-mCherry in SD

mitochondria360.087 -
N' NATIVEpr-GFP in SD
cytosol75.288 -
N' TEF2pr-VC and Cyto-VN in SD

#N/A0 -
C’ GFP library in SD+DTT
mitochondria66.971.23No -
C’ GFP library in SD+H2O2

mitochondria52.160.96No -
C’ GFP library in Starvation Media
mitochondria111.82.05Yes -
C’ GFP library on the background of Pup2-DaMP

mitochondria -
C’ GFP library on the background of CCT mutant

mitochondria34.45110.634508Yes
